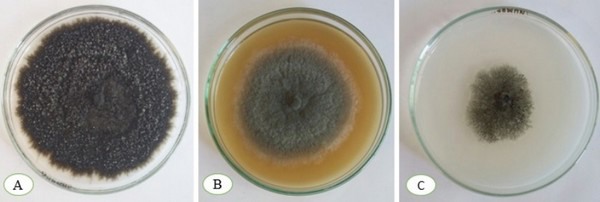

Magnolia grandiflora is a medicinal and horticultural plant species in the family Magnoliaceae which is native to North America (Li et al., 2013). Syringa reticulate is a tree in the family Oleaceae which is native to Japan (Green et al., 1995). During autumn 2017, leaf spots were observed on Magnolia grandiflora and Syringa reticulate in an ornamental garden in Hamedan province, Iran. Initial symptoms on M. grandiflora and S. reticulata leaves appeared as irregular, black and necrotic spots, often developing from the tip and sometimes from the edges of the leaves. These lesions slowly grew in size, and appeared long and blackish (Fig. 1).

Figure 1: Leaf spot symptoms caused by Phyllosticta capitalensis on a) Magnolia grandiflora and b) Syringa reticulata. Leaf spots caused by P. capitalensis 14 days after inoculation on c) Magnolia grandiflora and d) Syringa reticulata.
Symptomatic leaves were collected and transferred to the laboratory for further study. In order to identify the causal agent, small pieces were cut from the margin of diseased and healthy tissues of affected leaves. After surface disinfection, the pieces were transferred onto potato dextrose agar (PDA) medium at 27°C in the darkness for seven days. The isolates were transferred to saltwater nutrient agar (SNA) and malt extract agar (MEA) media. For each isolate, the size, colour and shape of 30 pycnidia and conidia, were recorded after 14 days. On PDA, colonies were initially white, gradually becoming greenish to dark green then black, on SNA, colonies were greenish to dark green and on MEA, colonies were grey to black (Fig. 2). Pycnidia with conidia were produced after 14 days. Pycnidia were globose, and brown to black. Conidia were hyaline, one-celled, ovoid to ellipsoid, with a short and thin apical appendage, measuring 9-11 × 5-6 µm (Fig. 3). On the basis of morphological characters, the isolates were identified as Phyllosticta capitalensis. As the cultural and morphological characters of the isolates were very similar, one isolate from each host was selected for molecular analysis. Genomic DNA was extracted as described by Moller et al. (1992). The ITS region was amplified using primers ITS1 and ITS4. A BLAST search using the sequence from the M. grandiflora isolate (GenBank Accession No. MG954332) showed 99.35 % identity with 100% cover to P. capitalensis (KM513574). The Syringa reticulata isolate (MF784271) had 99% identity with 99% cover to P. capitalensis (KP900294).
Figure 2: Phyllosticta capitalensis after 7 days on a) potato dextrose agar, b) malt extract agar and c) saltwater nutrient agar.
Pathogenicity tests were conducted on healthy leaves of M. grandiflora and S. reticulate in three replicates. Healthy leaves were sprayed with a conidial suspension (1 × 106 spores/ml), while control leaves were sprayed with sterile distilled water. Pathogenicity tests were done twice using the same conditions. Black and necrotic spots appeared after 14 days of incubation at 25°C and P. capitalensis was successfully re-isolated from artificially infected leaves, while no symptoms appeared on the control leaves (Fig. 1).

Figure 3: a) Pycnidia and b) conidia of Phyllosticta capitalensis after 14 days on nutrient agar.
Phyllosticta species include endophytes, saprobes and plant pathogens causing several disease symptoms including leaf and fruit spots (Guarnaccia et al., 2017). Phyllosticta capitalensis was previously reported as an endophyte on several species in the family Magnoliaceae (Promputtha et al., 2005). To our knowledge, this is the first report of Phyllosticta capitalensis as the causal agent of leaf spot on Magnolia grandiflora and Syringa reticulata.










